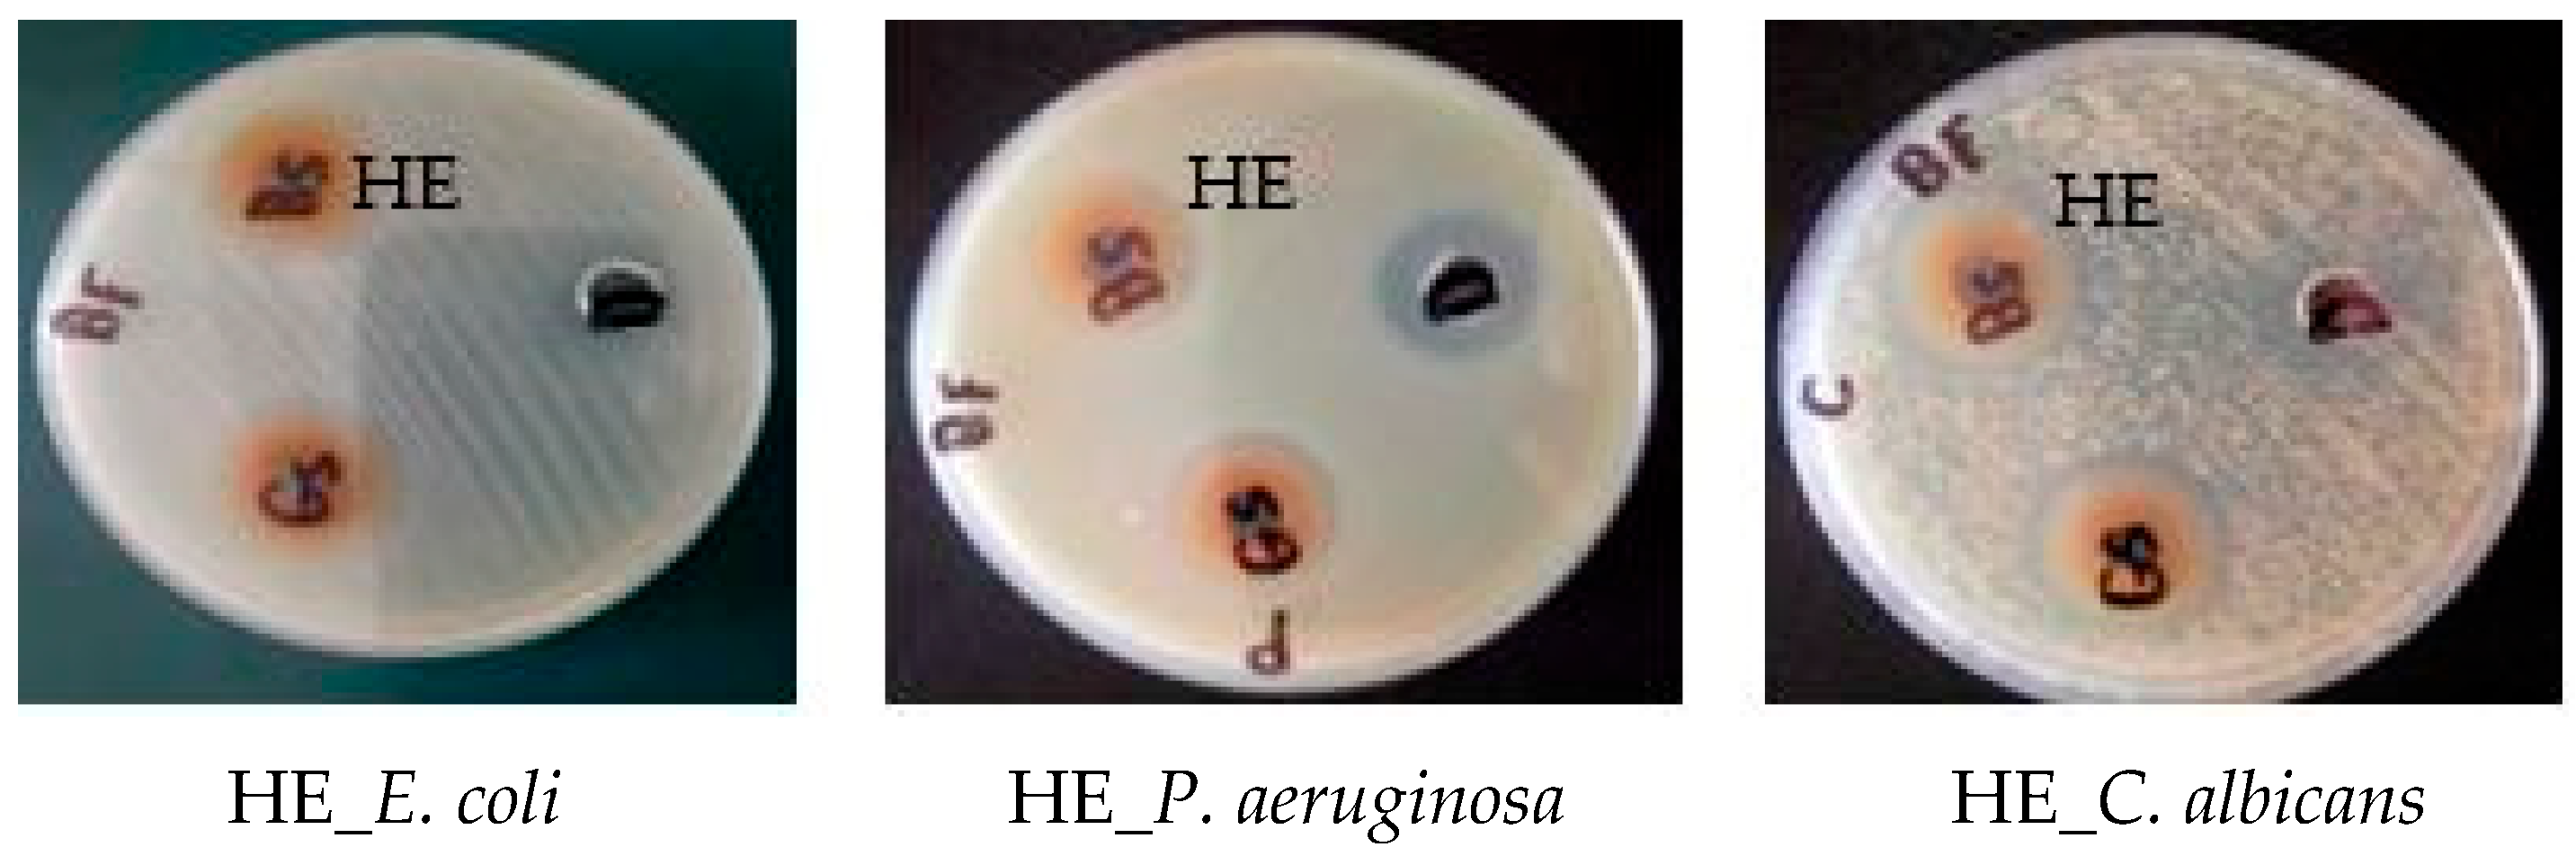
Pharmaceuticals 17 00724 g005

Chemical and Biological Characterization of the Ethyl Acetate Fraction from the Red Sea Marine Sponge Hymedesmia sp.
Abstract
1. Introduction
2. Results and Discussion
2.1. Characterization of the Isolated Compounds
2.2. Tentative Identification of Constituents of Hymedesmia sp. Ethyl Acetate Fraction by UPLC-ESI-MS/MS
Characterization of the Components of Hymedesmia sp. Ethyl Acetate Fraction
| No. | Compound Name | Rt (Min.) | Parent Ion (m/z) | MS2 Fragments (m/z) | Area% Total | Reference |
|---|---|---|---|---|---|---|
| 1 | * Uracil | 0.21 | 114 [M+2H]+ | 70 | 7.12 | [16] |
| 2 | Aminobutyric acid | 0.74 | 104 [M+H]+ | 59, 44, 43 | 7.12 | [16] |
| 3 | Threonine | 0.68 | 120 [M+H]+ | 102 [M+-H2O], 74, 70 | 1.92 | [17,18] |
| 4 | Threonine isomer | 0.78 | 120 [M+H]+ | 102 [M+-H2O], 84, 74, 70 | 0.29 | [17,18] |
| 5 | Kynurenine | 0.78 | 209 [M+H]+ | 164, 136, 128, 118, 136, 94 | 0.90 | [16,19] |
| 6 | Threonine isomer | 1.88 | 120 [M+H]+ | 102 [M+-H2O], 74, 56 | 0.56 | [17,18] |
| 7 | Uracil | 0.27 | 113 MS1 | 0.95 | [16] | |
| 8 | * Adenine | 0.80 | 137 [M+2H]+ | 119 [M++H-NH3]+, 109, 93, 66 | 7.62 | [16,20] |
| 9 | Adenine isomer | 0.94 | 137 [M++2H]+ | 119 [M++H-NH3]+, 109, 93, 66 | 0.98 | [20] |
| 10 | * Thymidine | 1.06 | 241 [M-H]− MS1 | 125 [thymine H] | 6.95 | [21] |
| 11 | * Thymine | 1.18 | 127 [M+H]+ | 110, 84, 56, 44 | 4.91 | [16] |
| 12 | L-phenylalanine | 1.21 | 166 [M+H]+ | 120 | 0.75 | [16] |
| 13 | 1-Pyroline-5-carboxylic acid | 1.36 | 114 [M+H]+ | 96 [M+H-H2O], 67 [M+H-COOH] | 1.19 | [16] |
| 14 | L-cysteine | 1.54 | 122 [M+H]+ | 105 [M+H-NH3] | 29.67 | [16] |
| 15 | 1-pyroline-5-carboxylic acid isomer | 1.71 | 114 [M+H]+ | 96 [M+H-H2O], 67 [M+H-COOH] | 0.35 | [16] |
| 16 | Asparagine | 1.79 | 131 [M-H]− | 85 [M-H-COOH], 69 [85-NH2] | 0.67 | [23] |
| 17 | 1-pyroline-5-carboxylic acid isomer | 2.04 | 114 [M+H]+ | 96 [M+H-H2O], 68 [M-COOH] | 0.25 | [16] |
| 18 | Thymine isomer | 2.06 | 127 [M+H]+ | 110, 84, 56, 44 | 0.38 | [16] |
| 19 | Thymine isomer | 2.10 | 127 [M+H]+ | 110, 84, 56, 44 | 0.54 | [16] |
| 20 | Thymidine isomer | 3.48 | 243 [M+H]+ 241 [M-H]− | 125 | 0.65 | [16] |
| 21 | S-sulfo-L-cysteine | 3.76 | 202 [M+H]+ | 185, 156, 128, 73, 46 | 0.30 | [16] |
| 22 | Kojic acid | 4.03 | 144 [M+2H]+ | 126 [M++2H-H2O], 115 [M++2H-CHO], 90.8, 65.8 | 1.95 | [24] |
| 23 | Kojic acid isomer | 4.08 | 144 [M+2H]+ | 127 [M++2H-H2O], 115 [M++2H-CHO], 90.8, 65.8 | 0.63 | [24] |
| 24 | Kojic acid isomer | 4.10 | 144 [M+2H]+ | 127 [M++2H-H2O], 115 [M++2H-CHO], 90.8, 65.8 | 0.53 | [24] |
| 25 | N-acetyl-L-cysteine | 4.27 | 164 [M+H]+ | 121, 102, 75 | 0.24 | [16] |
| 26 | Pipecolic acid | 5.45 | 130 [M+H]+ | 84, 56 | 0.37 | [16] |
| 27 | * Uridine | 8.71 | 245 [M+H]+ | 132, 112, 55, 43 | 4.53 | [27] |
| 28 | Brassicasterol | 15.18 | 381[M+H-H2O]+ | 274, 255, 105, 95, 55 | 2.18 | [25] |
| 29 | * Hymedesmoside | 29.96 | 757.8 [M+H]+ | 595, 459, 281, 239, 209, 85 | 2.08 | [13] |
2.3. Biological Activities of Hymedesmia sp. Ethyl Acetate (HE) Fraction
2.3.1. Antimicrobial Activity and Minimum Inhibitory Concentration (MIC)
2.3.2. Antioxidant Activity
2.3.3. Cytotoxic Activity
3. Materials and Methods
3.1. General Materials and Methods
3.2. Collection of Marine Sponge Samples
3.3. Extraction and Fractionation of Hymedesmia sp. Marine Sponge
3.4. Isolation of Compounds from the Ethyl Acetate Soluble Fraction of Hymedesmia sp.
3.4.1. Isolation and Identification of Compound 1 (Thymine)
3.4.2. Isolation and Identification of Compound 2 (Uracil)
3.4.3. Isolation and Identification of Compounds 3 and 4 (Thymidine and Uridine)
3.4.4. Isolation and Identification of Compound 5 (Adenine)
3.4.5. Isolation and Identification of Compound 6 (Hymedesmoside)
3.5. Biological Activities
3.5.1. Antioxidant Activity
3.5.2. Cytotoxic Activity
3.5.3. Antimicrobial Activity
Minimum Inhibitory Concentration Determination (MIC)
3.6. Statistical Analysis
4. Conclusions
Supplementary Materials
Author Contributions
Funding
Institutional Review Board Statement
Informed Consent Statement
Data Availability Statement
Acknowledgments
Conflicts of Interest
References
- Li, F.; Kelly, M.; Tasdemir, D. Chemistry, Chemotaxonomy and Biological Activity of the Latrunculid Sponges (Order Poecilosclerida, Family Latrunculiidae). Mar. Drugs 2021, 19, 27. [Google Scholar] [CrossRef] [PubMed]
- Bian, C.; Wang, J.; Zhou, X.; Wu, W.; Guo, R. Recent advances on marine alkaloids from sponges. Chem. Biodivers. 2020, 17, e2000186. [Google Scholar] [CrossRef] [PubMed]
- Ivanchina, N.V.; Kalinin, V.I. Triterpene and Steroid Glycosides from Marine Sponges (Porifera, Demospongiae): Structures, Taxonomical Distribution, Biological Activities. Molecules 2023, 28, 2503. [Google Scholar] [CrossRef] [PubMed]
- Esposito, R.; Federico, S.; Bertolino, M.; Zupo, V.; Costantini, M. Marine Demospongiae: A Challenging Treasure of Bioactive Compounds. Mar. Drugs 2022, 20, 244. [Google Scholar] [CrossRef] [PubMed]
- Said, A.A.E.; Mahmoud, B.K.; Attia, E.Z.; Abdelmohsen, U.R.; Fouad, M.A. Bioactive natural products from marine sponges belonging to family Hymedesmiidae. RSC Adv. 2021, 11, 16179. [Google Scholar] [CrossRef] [PubMed]
- Al-Saleem, M.S.M.; Hassan, W.H.B.; El Sayed, Z.I.; Abdel-Aal, M.M.; Abdel-Mageed, W.M.; Abdelsalam, E.; Abdelaziz, S. Metabolic Profiling and In Vitro Assessment of the Biological Activities of the Ethyl Acetate Extract of Penicillium chrysogenum “Endozoic of Cliona sp. Marine Sponge” from the Red Sea (Egypt). Mar. Drugs 2022, 20, 326. [Google Scholar] [CrossRef] [PubMed]
- Zhao, H.-Q.; Wang, X.; Li, H.-M.; Yang, B.; Yang, H.-J.; Huang, L. Characterization of nucleosides and nucleobases in natural cordyceps by HILIC–ESI/TOF/MS and HILIC–ESI/MS. Molecules 2013, 18, 9755. [Google Scholar] [CrossRef] [PubMed]
- Kuś, P.M.; Rola, R. LC-QqQ-MS/MS methodology for determination of purine and pyrimidine derivatives in unifloral honeys and application of chemometrics for their classification. Food Chem. 2021, 348, 129076. [Google Scholar] [CrossRef] [PubMed]
- Shaala, L.A.; Youssef, D.T.; Badr, J.M.; Harakeh, S.M.; Genta-Jouve, G. Bioactive diketopiperazines and nucleoside derivatives from a sponge-derived Streptomyces species. Mar. Drugs 2019, 17, 584. [Google Scholar] [CrossRef]
- Cao, X.; Lintelmann, J.; Padoan, S.; Bauer, S.; Huber, A.; Mudan, A.; Oeder, S.; Adam, T.; Di Bucchianico, S.; Zimmermann, R. Adenine derivatization for LC-MS/MS epigenetic DNA modifications studies on monocytic THP-1 cells exposed to reference particulate matter. Anal. Biochem. 2021, 618, 114127. [Google Scholar] [CrossRef]
- Durie, D.; Yeh, E.; McIntosh, N.; Fisher, L.; Bulman, D.E.; Birnboim, H.C.; Chakraborty, P.; Al-Dirbashi, O.Y. Quantification of DNA in neonatal dried blood spots by adenine tandem mass spectrometry. Anal. Chem. 2018, 90, 801–806. [Google Scholar] [CrossRef] [PubMed]
- Nogueira, G.; Favrelle, A.; Bria, M.; Ramalho, J.P.P.; Mendes, P.J.; Valente, A.; Zinck, P. Adenine as an organocatalyst for the ring-opening polymerization of lactide: Scope, mechanism and access to adenine-functionalized polylactide. React. Chem. Eng. 2016, 1, 508–520. [Google Scholar] [CrossRef]
- Elkhayat, E.S.; Mohamed, G.A.; Ibrahim, S.R.M. Activity and Structure Elucidation of Ceramides. Curr. Bioact. Compd. 2012, 8, 370–409. [Google Scholar] [CrossRef]
- Quiao, M.A.D.; Uy, M.M. Pyrimidines from the Philippine marine sponge Aaptos suberitoides. Int. J. Sci. Eng. Res. 2013, 4, 1–4. [Google Scholar] [CrossRef]
- Zhou, X.; Lin, X.; Guo, X.; Yang, B.; Xian-Wen, Y.; Liu, Y. Chemical Constituents of the Sponge Mycale Species from South China Sea. Rec. Nat. Prod. 2013, 7, 119. [Google Scholar]
- Piraud, M.; Vianey-Saban, C.; Petritis, K.; Elfakir, C.; Steghens, J.P.; Morla, A.; Bouchu, D. ESI-MS/MS analysis of underivatised amino acids: A new tool for the diagnosis of inherited disorders of amino acid metabolism. Fragmentation study of 79 molecules of biological interest in positive and negative ionisation mode. Rapid Commun. Mass Spectrom. 2003, 17, 1297–1311. [Google Scholar] [CrossRef] [PubMed]
- Farajmand, B.; Bahrami, H. Electron ionization of serine and threonine: A discussion about peak intensities. Phys. Chem. Res. 2016, 4, 539–551. [Google Scholar]
- Le, A.; Ng, A.; Kwan, T.; Cusmano-Ozog, K.; Cowan, T.M. A rapid, sensitive method for quantitative analysis of underivatized amino acids by liquid chromatography–tandem mass spectrometry (LC–MS/MS). J. Chromatogr. B 2014, 944, 166–174. [Google Scholar] [CrossRef]
- Vazquez, S.; Truscott, R.J.; Richard, A.; Weimann, A.; Sheil, M.M. A study of kynurenine fragmentation using electrospray tandem mass spectrometry. J. Am. Soc. Mass Spectrom. 2001, 12, 786–794. [Google Scholar] [CrossRef]
- Sadr-Arani, L.; Mignon, P.; Chermette, H.; Abdoul-Carime, H.; Farizon, B.; Farizon, M. Fragmentation mechanisms of cytosine, adenine and guanine ionized bases. Phys. Chem. Chem. Phys. 2015, 17, 11813–11826. [Google Scholar] [CrossRef]
- Kipper, K.; Hecht, M.; Antunes, N.J.; Fairbanks, L.D.; Levene, M.; Kalkan Uçar, S.; Schaefer, A.; Blakely, E.L.; Bax, B.E. Quantification of plasma and urine thymidine and 2′-deoxyuridine by LC-MS/MS for the pharmacodynamic evaluation of erythrocyte encapsulated thymidine phosphorylase in patients with mitochondrial neurogastrointestinal encephalomyopathy. J. Clin. Med. 2020, 9, 788. [Google Scholar] [CrossRef] [PubMed]
- van Breemen, R.B.; Tan, Y.; Lai, J.; Huang, C.-R.; Zhao, X. Immobilized thymine chromatography–mass spectrometry of oligonucleotides. J. Chromatogr. A 1998, 806, 67–76. [Google Scholar] [CrossRef]
- Nielsen, N.J.; Granby, K.; Hedegaard, R.V.; Skibsted, L.H. A liquid chromatography–tandem mass spectrometry method for simultaneous analysis of acrylamide and the precursors, asparagine and reducing sugars in bread. Anal. Chim. Acta 2006, 557, 211–220. [Google Scholar] [CrossRef]
- Varga, E.; Glauner, T.; Berthiller, F.; Krska, R.; Schuhmacher, R.; Sulyok, M. Development and validation of a (semi-) quantitative UHPLC-MS/MS method for the determination of 191 mycotoxins and other fungal metabolites in almonds, hazelnuts, peanuts and pistachios. Anal. Bioanal. Chem. 2013, 405, 5087–5104. [Google Scholar] [CrossRef] [PubMed]
- Münger, L.H.; Boulos, S.; Nyström, L. UPLC-MS/MS based identification of dietary steryl glucosides by investigation of corresponding free sterols. Front. Chem. 2018, 6, 342. [Google Scholar] [CrossRef] [PubMed]
- Hassan, S.T. Brassicasterol with Dual Anti-Infective Properties against HSV-1 and Mycobacterium tuberculosis, and Cardiovascular Protective Effect: Nonclinical In Vitro and In Silico Assessments. Biomedicines 2020, 8, 132. [Google Scholar] [CrossRef]
- Kulkarni, R.R.; Kim, J.H.; Kim, Y.H.; Oh, S.; Na, M. Isolation and Structure Determination of an Imidazo-pyrimidine, 5-Chlorocavernicolin, Maleimide oximes and Nucleosides from a Marine Sponge Extract. Nat. Prod. Sci. 2015, 21, 25–29. [Google Scholar]
- Aldawsari, M.F.; Khafagy, E.-S.; Saqr, A.A.; Alalaiwe, A.; Abbas, H.A.; Shaldam, M.A.; Hegazy, W.A.H.; Goda, R.M. Tackling Virulence of Pseudomonas aeruginosa by the Natural Furanone Sotolon. Antibiotics 2021, 10, 871. [Google Scholar] [CrossRef] [PubMed]
- Khayat, M.T.; Elbaramawi, S.S.; Nazeih, S.I.; Safo, M.K.; Khafagy, E.-S.; Ali, M.A.M.; Abbas, H.A.; Hegazy, W.A.H.; Seleem, N.M. Diminishing the Pathogenesis of the Food-Borne Pathogen Serratia marcescens by Low Doses of Sodium Citrate. Biology 2023, 12, 504. [Google Scholar] [CrossRef]
- Barbosa, F.; Pinto, E.; Kijjoa, A.; Pinto, M.; Sousa, E. Targeting antimicrobial drug resistance with marine natural products. Int. J. Antimicrob. Agents 2020, 56, 106005. [Google Scholar] [CrossRef]
- De Oliveira, A.M.; Mesquita, M.d.S.; da Silva, G.C.; de Oliveira Lima, E.; de Medeiros, P.L.; Paiva, P.M.G.; Souza, I.A.d.; Napoleão, T.H. Evaluation of toxicity and antimicrobial activity of an ethanolic extract from leaves of Morus alba L.(Moraceae). Evid. Based Complement. Altern. Med. 2015, 2015, 513978. [Google Scholar] [CrossRef] [PubMed]
- Sartoratto, A.; Machado, A.L.M.; Delarmelina, C.; Figueira, G.M.; Duarte, M.C.T.; Rehder, V.L.G. Composition and antimicrobial activity of essential oils from aromatic plants used in Brazil. Braz. J. Microbiol. 2004, 35, 275–280. [Google Scholar] [CrossRef]
- Vogel-Adghough, D.; Stahl, E.; Návarová, H.; Zeier, J. Pipecolic acid enhances resistance to bacterial infection and primes salicylic acid and nicotine accumulation in tobacco. Plant Signal. Behav. 2013, 8, e26366. [Google Scholar] [CrossRef] [PubMed]
- Brtko, J. Biological functions of kojic acid and its derivatives in medicine, cosmetics, and food industry: Insights into health aspects. Arch. Pharm. 2022, 355, e2200215. [Google Scholar] [CrossRef] [PubMed]
- Xie, M.; Song, Q.; Zhao, H. Investigation on the surface-active and antimicrobial properties of a natural glycolipid product. Food Funct. 2021, 12, 11537–11546. [Google Scholar] [CrossRef] [PubMed]
- Flieger, J.; Flieger, W.; Baj, J.; Maciejewski, R. Antioxidants: Classification, natural sources, activity/capacity measurements, and usefulness for the synthesis of nanoparticles. Materials 2021, 14, 4135. [Google Scholar] [CrossRef] [PubMed]
- Balakrishnan, D.; Kandasamy, D.; Nithyanand, P. A review on antioxidant activity of marine organisms. Int. J. ChemTech Res. 2014, 6, 3431–3436. [Google Scholar]
- Sharma, G.N.; Gupta, G.; Sharma, P. A comprehensive review of free radicals, antioxidants, and their relationship with human ailments. Crit. Rev.™ Eukaryot. Gene Expr. 2018, 28, 139–154. [Google Scholar] [CrossRef] [PubMed]
- El-Shitany, N.A.; Shaala, L.A.; Abbas, A.T.; Abdel-Dayem, U.A.; Azhar, E.I.; Ali, S.S.; Van Soest, R.W.; Youssef, D.T. Evaluation of the anti-inflammatory, antioxidant and immunomodulatory effects of the organic extract of the red sea marine sponge Xestospongia testudinaria against carrageenan induced rat paw inflammation. PLoS ONE 2015, 10, e0138917. [Google Scholar] [CrossRef]
- Winarsi, H.; Yuniaty, A. Antioxidant exploration in cardamom rhizome potential as a functional food ingredient. IOP Conf. Ser. Earth Environ.Sci. 2019, 217, 012019. [Google Scholar] [CrossRef]
- Kim, J.-H.; Jang, H.-J.; Cho, W.-Y.; Yeon, S.-J.; Lee, C.-H. In vitro antioxidant actions of sulfur-containing amino acids. Arab. J. Chem. 2020, 13, 1678–1684. [Google Scholar] [CrossRef]
- Hassan, W.H.; El Sayed, Z.I.; Al-Wahaibi, L.H.; Abdel-Aal, M.M.; Abdel-Mageed, W.M.; Abdelsalam, E.; Abdelaziz, S. Metabolites Profiling and In Vitro Biological Characterization of Different Fractions of Cliona sp. Marine Sponge from the Red Sea Egypt. Molecules 2023, 28, 1643. [Google Scholar] [CrossRef] [PubMed]
- Rahman, M.A.; Dash, R.; Sohag, A.A.M.; Alam, M.; Rhim, H.; Ha, H.; Moon, I.S.; Uddin, M.J.; Hannan, M.A. Prospects of marine sterols against pathobiology of Alzheimer’s disease: Pharmacological insights and technological advances. Mar. Drugs 2021, 19, 167. [Google Scholar] [CrossRef] [PubMed]
- Mbaoji, F.N.; Nweze, J.A.; Yang, L.; Huang, Y.; Huang, S.; Onwuka, A.M.; Peter, I.E.; Mbaoji, C.C.; Jiang, M.; Zhang, Y. Novel Marine Secondary Metabolites Worthy of Development as Anticancer Agents: A Review. Molecules 2021, 26, 5769. [Google Scholar] [CrossRef] [PubMed]
- Vizetto-Duarte, C.; Castelo-Branco, P.; Custódio, L. Marine natural products as a promising source of therapeutic compounds to target cancer stem cells. Curr. Med. Chem. 2021, 28, 4343–4355. [Google Scholar] [CrossRef] [PubMed]
- Veríssimo, A.C.S.; Pacheco, M.; Silva, A.M.S.; Diana, C.G.A.P. Secondary Metabolites from Marine Sources with Potential Use as Leads for Anticancer Applications. Molecules 2021, 26, 4292. [Google Scholar] [CrossRef] [PubMed]
- Srisawat, T.; Chumkaew, P.; Heed-Chim, W.; Sukpondma, Y.; Kanokwiroon, K. Phytochemical screening and cytotoxicity of crude extracts of Vatica diospyroides symington type LS. Trop. J. Pharm. Res. 2013, 12, 71–76. [Google Scholar] [CrossRef]
- Abdelhameed, R.F.A.; Habib, E.S.; Eltahawy, N.A.; Hassanean, H.A.; Ibrahim, A.K.; Mohammed, A.F.; Fayez, S.; Hayallah, A.M.; Yamada, K.; Behery, F.A.; et al. New Cytotoxic Natural Products from the Red Sea Sponge Stylissa carteri. Mar. Drugs 2020, 18, 241. [Google Scholar] [CrossRef] [PubMed]
- Phan, C.-W.; Wang, J.-K.; Cheah, S.-C.; Naidu, M.; David, P.; Sabaratnam, V. A review on the nucleic acid constituents in mushrooms: Nucleobases, nucleosides and nucleotides. Crit. Rev. Biotechn. 2018, 38, 762–777. [Google Scholar] [CrossRef]
- Momo, C.H.K.; Mboussaah, A.D.K.; François Zambou, N.; Shaiq, M.A. New pyran derivative with antioxidant and anticancer properties isolated from the probiotic Lactobacillus plantarum H24 strain. Nat. Prod. Res. 2022, 36, 909–917. [Google Scholar] [CrossRef]
- Walczak, K.; Wnorowski, A.; Turski, W.A.; Plech, T. Kynurenic acid and cancer: Facts and controversies. Cell Mol. Life Sci. 2020, 77, 1531–1550. [Google Scholar] [CrossRef] [PubMed]
- Hassan, W.H.; Abdelaziz, S.; Al Yousef, H.M. Chemical composition and biological activities of the aqueous fraction of Parkinsonea aculeata L. growing in Saudi Arabia. Arab. J. Chem. 2019, 12, 377–387. [Google Scholar] [CrossRef]
- Al-Yousef, H.M.; Hassan, W.H.; Abdelaziz, S.; Amina, M.; Adel, R.; El-Sayed, M.A. UPLC-ESI-MS/MS profile and antioxidant, cytotoxic, antidiabetic, and antiobesity activities of the aqueous extracts of three different Hibiscus Species. J. Chem. 2020, 2020, 6749176. [Google Scholar] [CrossRef]
- Gülcin, I.; Küfrevioglu, O.; Oktay, M.; Büyükokuroglu, M. Study of some antioxidant parameters in mice livers affected with Urtica Pilulifer extracts. J. Ethnopharmacol. 2004, 90, 205–215. [Google Scholar] [PubMed]
- Yen, G.C.; Duh, P.D. Scavenging effect of methanolic extracts of peanut hulls on free-radical and active-oxygen species. J. Agric. Food Chem. 1994, 42, 629–632. [Google Scholar] [CrossRef]
- Gomha, S.M.; Salah, T.A.; Abdelhamid, A.O. Synthesis, characterization, and pharmacological evaluation of some novel thiadiazoles and thiazoles incorporating pyrazole moiety as anticancer agents. Monatsh. fur Chem./Chem. Mon. 2015, 146, 149–158. [Google Scholar] [CrossRef]
- Mosmann, T. Rapid colorimetric assay for cellular growth and survival: Application to proliferation and cytotoxicity assays. J. Immunol. Methods 1983, 65, 55–63. [Google Scholar] [CrossRef] [PubMed]
- Kumar, P.; Nagarajan, A.; Uchil, P.D. Analysis of cell viability by the MTT assay. Cold Spring Harb. Protoc. 2018, 2018, pdb-prot095505. [Google Scholar] [CrossRef]
- Hindler, J.; Howard, B.; Keiser, J. Antimicrobial agents and antimicrobial susceptibility testing. In Howard BJ. Clinical and Pathogenic Microbiology, 2nd ed.; Mosby: St. Louis, MO, USA, 1994. [Google Scholar]
- Choudhary, M.I.; Thomsen, W.J. Bioassay Techniques for Drug Development; CRC Press: Boca Raton, FL, USA, 2001. [Google Scholar]
- Himratul-Aznita, W.H.; Mohd-Al-Faisal, N.; Fathilah, A. Determination of the percentage inhibition of diameter growth (PIDG) of Piper betle crude aqueous extract against oral Candida species. J. Med. Plant Res. 2011, 5, 878–884. [Google Scholar]
- Wikler, M.A. Methods for dilution antimicrobial susceptibility tests for bacteria that grow aerobically: Approved standard. CLSI (NCCLS) 2006, 26, M7–A7. [Google Scholar]
- Wayne, P. Reference Method for Broth Dilution Antifungal Susceptibility Testing of Yeasts, Approved Standard; CLSI Document M27-A2; Clinical and Laboratory Standards Institute: Wayne, PA, USA, 2002. [Google Scholar]
- Yoshida, T.; Jono, K.; Okonogi, K. Modified agar dilution susceptibility testing method for determining in vitro activities of antifungal agents, including azole compounds. Antimicrob. Agents Chemother. 1997, 41, 1349–1351. [Google Scholar] [CrossRef] [PubMed]

| Microorganism/ Fraction | Inhibition Zone (IZ mm) Diameter (mean ± SD)/Minimum Inhibitory Concentration (MIC µg/mL) | ||||||||
|---|---|---|---|---|---|---|---|---|---|
| Gram Positive Bacteria | Gram Negative Bacteria | Fungus | |||||||
| Staphylococcus aureus ATCC 5368 | Escherichia coli ATCC 10536 | Pseudomonas aeruginosa ATCC 27853 | Candida albicans ATCC 10231 | ||||||
| IZ | MIC | IZ | MIC | IZ | MIC | IZ | MIC | ||
| Hymdesmia sp. | Ethyl acetate (HE) | 22 ± 0.69 | 62.5 ± 0.88 | 22 ± 0.83 | 125 ± 0.98 | 21 ± 0.62 | 31.25 ± 0.32 | 25 ± 0.59 | 3000 ± 0.38 |
| Ciprofloxacin | - | 1.56 ± 1.2 | - | 3.125 ± 0.89 | - | 3.125 ± 0.24 | - | - | |
| Fluconazole | - | - | - | - | - | - | 42 ± 0.58 | 50 ± 0.24 | |
| DMSO (Solvent) | 10 | 10 | 19 | 12 | |||||
| Cell Line | IC50 (µg/mL) | |
|---|---|---|
| Tested Ethyl Acetate Fraction (HE) of Hymedesmia sp. | ||
| HE | Vinblastine Sulphate | |
| HCT-116 (Colon carcinoma) | 13.5 ± 0.8 | 2.34 ± 0.28 |
| HEP-2 (Human Larynx carcinoma) | 25.3 ± 2.4 | 6.61 ± 0.59 |
Disclaimer/Publisher’s Note: The statements, opinions and data contained in all publications are solely those of the individual author(s) and contributor(s) and not of MDPI and/or the editor(s). MDPI and/or the editor(s) disclaim responsibility for any injury to people or property resulting from any ideas, methods, instructions or products referred to in the content. |
© 2024 by the authors. Licensee MDPI, Basel, Switzerland. This article is an open access article distributed under the terms and conditions of the Creative Commons Attribution (CC BY) license (https://creativecommons.org/licenses/by/4.0/).
Share and Cite
El Sayed, Z.I.; Hassan, W.H.B.; Abdel-Aal, M.M.; Al-Massarani, S.M.; Abdel-Mageed, W.M.; Basudan, O.A.; Parveen, M.; Abdelsalam, E.; Abdelaziz, S. Chemical and Biological Characterization of the Ethyl Acetate Fraction from the Red Sea Marine Sponge Hymedesmia sp. Pharmaceuticals 2024, 17, 724. https://doi.org/10.3390/ph17060724
El Sayed ZI, Hassan WHB, Abdel-Aal MM, Al-Massarani SM, Abdel-Mageed WM, Basudan OA, Parveen M, Abdelsalam E, Abdelaziz S. Chemical and Biological Characterization of the Ethyl Acetate Fraction from the Red Sea Marine Sponge Hymedesmia sp. Pharmaceuticals. 2024; 17(6):724. https://doi.org/10.3390/ph17060724
Chicago/Turabian StyleEl Sayed, Zeinab I., Wafaa H. B. Hassan, Mahmoud M. Abdel-Aal, Shaza M. Al-Massarani, Wael M. Abdel-Mageed, Omer A. Basudan, Mehtab Parveen, Eman Abdelsalam, and Sahar Abdelaziz. 2024. "Chemical and Biological Characterization of the Ethyl Acetate Fraction from the Red Sea Marine Sponge Hymedesmia sp." Pharmaceuticals 17, no. 6: 724. https://doi.org/10.3390/ph17060724
APA StyleEl Sayed, Z. I., Hassan, W. H. B., Abdel-Aal, M. M., Al-Massarani, S. M., Abdel-Mageed, W. M., Basudan, O. A., Parveen, M., Abdelsalam, E., & Abdelaziz, S. (2024). Chemical and Biological Characterization of the Ethyl Acetate Fraction from the Red Sea Marine Sponge Hymedesmia sp. Pharmaceuticals, 17(6), 724. https://doi.org/10.3390/ph17060724

